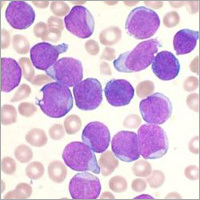
तीव्र ल्यूकेमिया आयुर्वेदिक चिकित्सा

पाउडर आयुर्वेदिक ब्रेन डिसऑर्डर की दवा
प्राइस: 14999.00 INR / Unit
(14999.00 INR + 0% GST)नवीनतम कीमत पता करें
स्टॉक में
| फंक्शन | अन्य |
| प्रॉडक्ट टाइप | आयुर्वेदिक औषधि |
| खुराक | AS per Physician |
| भौतिक रूप | पाउडर |
| आपूर्ति की क्षमता | 100प्रति सप्ताह |
विस्तृत जानकारी
| फंक्शन | अन्य |
| प्रॉडक्ट टाइप | आयुर्वेदिक औषधि |
| खुराक | AS per Physician |
| भौतिक रूप | पाउडर |
| आपूर्ति की क्षमता | 100प्रति सप्ताह |
| डिलीवरी का समय | 7दिन |
कंपनी का विवरण
होप आयुर्वेदिक मेडिसिन्स प्राइवेट लिमिटेड, 2006 में महाराष्ट्र के पुणे में स्थापित, भारत में आयुर्वेदिक दवाएं और उत्पाद का टॉप निर्माता,निर्यातक,आपूर्तिकर्ता,थोक विक्रेता है। होप आयुर्वेदिक मेडिसिन्स प्राइवेट लिमिटेड ट्रेड इंडिया के सूचीबद्ध उत्पादों के सत्यापित और विश्वसनीय विक्रेताओं में से एक है। आपूर्ति और व्यापार के अपने व्यापक अनुभव के साथ, होप आयुर्वेदिक मेडिसिन्स प्राइवेट लिमिटेड ने उच्च गुणवत्ता आदि के साथ बाजार में अपने लिए एक प्रतिष्ठित नाम बनाया है। ग्राहक केंद्रित दृष्टिकोण पर ध्यान केंद्रित करते हुए, होप आयुर्वेदिक मेडिसिन्स प्राइवेट लिमिटेड की अखिल भारतीय उपस्थिति है और पूरे देश में एक विशाल उपभोक्ता आधार को पूरा करता है। होप आयुर्वेदिक मेडिसिन्स प्राइवेट लिमिटेड से ट्रेड इंडिया के गुणवत्ता-सुनिश्चित उत्पादों () को थोक में खरीदें।
व्यापार के प्रकार
निर्माता, निर्यातक, आपूर्तिकर्ता, थोक विक्रेता
कर्मचारी संख्या
100
स्थापना
2006
कार्य दिवस
सोमवार से रविवार
जीएसटी सं
27AABCH7683Q1ZQ
Explore in english - Ayurvedic Brain Disorder Medicine
विक्रेता विवरण
होप आयुर्वेदिक मेडिसिन्स प्राइवेट लिमिटेड
जीएसटी सं
27AABCH7683Q1ZQ
नाम
र. डी. काटकर
पता
पीयू हाइट्स १स्ट फ्लोर नियर मेजर राणे स्कूल २ कम फ्रॉम शिवाजीनगर रेलवे स्टेशन, संगमवादी, पुणे, महाराष्ट्र, 411003, भारत
गलत विवरण की रिपोर्ट करें